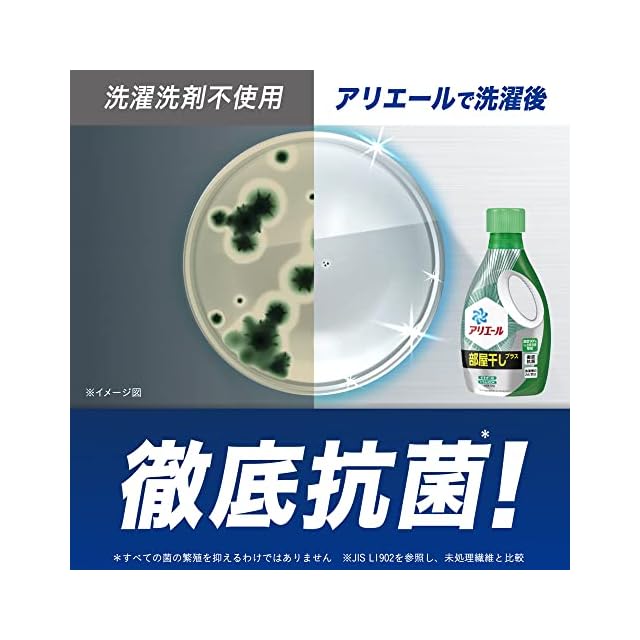

1/8
P&G アリエールジェル部屋干しプラス 詰替超特大 945g
¥2,025 税込
SOLD OUT
この商品は送料無料です。
【商品概要】
部屋干し5年ぶりの大改良!
煮沸レベル消臭。
液体アリエール初! 洗濯機まるごと除菌
原材料:界面活性剤(26%:ポリオキシエチレンアルキルエーテル、直鎖アルキルベンゼンスルホン酸塩、純せっけん分(脂肪酸塩))、安定化剤、アルカリ剤、分散剤、水軟化剤、蛍光増白剤、酵素
ブランド:P&G
【商品詳細】
ブランド:P&G
商品種別:液体洗剤
商品名:P&G アリエールジェル部屋干しプラス 詰替超特大 945g
製造元:P&G
商品番号:4987176117960
色:マルチカラー
梱包サイズ:52.2cm
-
レビュー
(0)
-
送料・配送方法について
-
お支払い方法について
¥2,025 税込
SOLD OUT
最近チェックした商品
同じカテゴリの商品
セール中の商品
その他の商品